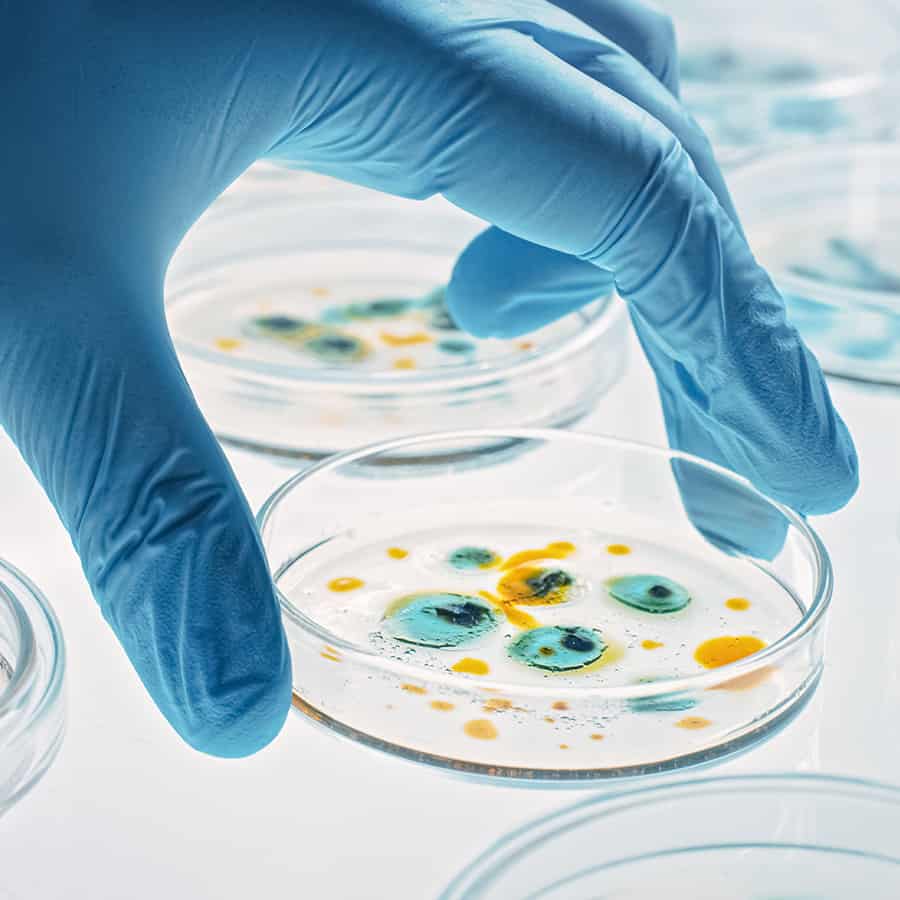

Interested in Aquaculture?
Our approach to aquaculture targets water quality, increased yields, and enhanced performance.

Unlocking Growth Potential
Aquaculture is the fastest growing food production system in the world. Our in-depth knowledge of water quality has been extended and applied to this sector.
Learn More about our approach

Revolutionizing Aquaculture
Our products contain scientifically selected microorganisms chosen for the combined need to enhance performance, improve water quality, and aid in ammonia and sludge reduction. The microorganisms are natural, safe, and the broad range of activity allows for growth in various water temperatures, salinity levels, and different ecological environments.
Learn More About our programs

Real Science Means Real
Our laboratory is your laboratory! Our team of over 20 microbiologists is always actively seeking new ways to extend microbiology solutions to diverse applications. We love solving new problems.
Contact Us
Interested in Aquaculture?
Our approach to aquaculture targets water quality, increased yields, and enhanced performance.
Approach

Unlocking Growth Potential
Aquaculture is the fastest growing food production system in the world. Our in-depth knowledge of water quality has been extended and applied to this sector.
Learn More about our approach
Product
Revolutionizing Aquaculture
Our products contain scientifically selected microorganisms chosen for the combined need to enhance performance, improve water quality, and aid in ammonia and sludge reduction. The microorganisms are natural, safe, and the broad range of activity allows for growth in various water temperatures, salinity levels, and different ecological environments.
Learn More About our products
Research & Development

Real Science Means Real Experts.
Our laboratory is your laboratory! Our team of over 20 microbiologists is always actively seeking new ways to extend microbiology solutions to diverse applications. We love solving new problems.









